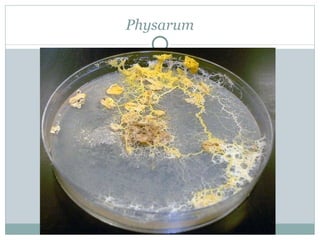
Physarum

Slime molds spend most of their life cycle as single-celled amoebas but aggregate together to form a multicellular mass called a plasmodium when nutrients are scarce. The plasmodium is able to migrate in search of food and later forms spore-bearing fruiting bodies for reproduction. Some slime molds like Physarum remain separate within the plasmodium while others like Dictyostelium fuse their membranes and cytoplasm to form a single coenocytic cell.